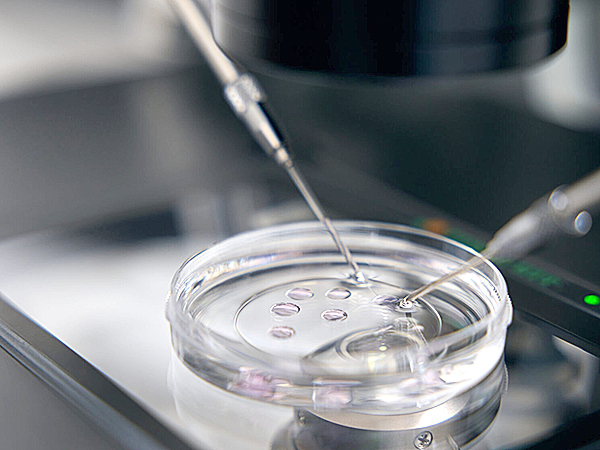

Novinky / Aktuality
Pozvánka na zákaznické dny AKNEL
Společnost AKNEL Group a.s. si vás dovoluje pozvat na tuto zákaznickou akci, kde budeme prezentovat zcela nové...
Nový katalog AKNEL 2025
Zcela nový katalog je právě uvolněn k náhledu a přehledu našeho sortimentu. Aktuální produkty můžete nalézt vše na...
Digitalizace ve společnosti AKNEL
Naše společnost Aknel úspěšně získala podporu z prostředků Evropské unie na projekt „Digitalizace ve společnosti...
Naše produkty a služby
Společnost
Česká výrobní společnost, která patří mezi významné české výrobce průmyslových maziv, odsávacích zařízení a technologických celků. Naše motto zní „od myšlenky k realizaci“, tím jsme unikátní. Aktuálně působíme na trhu více než 25 let.
Zaujala Vás naše komplexní nabídka produktů?
Kontaktujte nás a my Vás vybavíme.